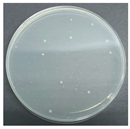
Polymers 17 00905 i009
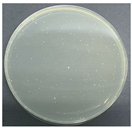
Polymers 17 00905 i014

Development and Performance of Negative Ion Functional Blended Yarns and Double-Sided Knitted Fabrics Based on ZnO/TM/PET Fiber
Abstract
1. Introduction
2. Experiment
2.1. Experimental Materials
2.2. Preparation of ZnO/TM/PET Negative Ion Functional Fiber
2.3. Spinning of Negative Ion Polyester/Cotton-Blended Yarn
2.4. Weaving Process of Negative Ion Knitted Fabric
2.5. Test Methods
2.5.1. SEM and EDS
2.5.2. Yarn Hairiness Index Testing
2.5.3. Wear Resistance Testing
2.5.4. Mechanical Properties Testing
2.5.5. Air Permeability and Moisture Permeability
2.5.6. Negative Ion Emission Testing
2.5.7. Far-Infrared Performance Testing
2.5.8. Evaluation of Antimicrobial Properties
3. Results and Discussion
3.1. SEM and EDS Analysis of ZnO/TM Composite and ZnO/TM/PET Fiber
3.2. Effect of Blending Ratio on Properties of Negative Ion Functional Blended Yarn
3.2.1. Hairiness Index Analysis
3.2.2. Mechanical Property Analysis
3.2.3. Negative Ion Release Analysis
3.3. Effect of Yarn Ratio and Fabric Structure on Properties of Double-Sided Knitted Fabric with Negative Ion Function
3.3.1. Mechanical Properties Analysis
3.3.2. Pilling Resistance Analysis
3.3.3. Air Permeability and Moisture Permeability Analysis
3.3.4. Negative Ion Release Property
3.3.5. Far-Infrared Performance
3.3.6. Antimicrobial Performance
4. Conclusions
Author Contributions
Funding
Institutional Review Board Statement
Data Availability Statement
Conflicts of Interest
References
- Cheng, W.P.; Dong, J.; Li, P.F. Research progress in the preparation and application of piezoelectric fibers. J. Synth. Fiber Ind. 2024, 47, 61–66. [Google Scholar]
- Liang, X.L. Progress in the application of high-performance graphene materials in textile field. Prog. Text. Sci. Technol. 2020, 7, 26–29. [Google Scholar]
- Yang, H.B. Preparation and Structural Properties of Polyamide 6 Based Elastic Fibers. Master’s Thesis, Donghua University, Shanghai, China, 2022. [Google Scholar]
- Jradi, M.; Riffat, S. Testing and performance analysis of a hollow fiber-based core for evaporative cooling and liquid desiccant dehumidification. Int. J. Green Energy 2016, 13, 1388–1399. [Google Scholar]
- Yu, W.G.; Zhang, X.Y.; Gao, X.F.; Liu, H.; Zhang, X. Fabrication of high-strength PET fibers modified with graphene oxide of varying lateral size. J. Mater. Sci. 2020, 55, 8940–8953. [Google Scholar]
- Chen, Q.S.; Qu, M.J.; Wang, H.; Tang, P.; Liu, R.K.; Zhang, R.; Bin, Y.Z. Preparation and aggregate structure of polyacrylonitrile and microcrystalline cellulose hygroscopic thermal composite fibers. Polym. Int. 2022, 72, 406–415. [Google Scholar]
- Park, J.H.; Rutledge, G.C. Ultrafine high performance polyethylene fibers. J. Mater. Sci. 2018, 53, 3049–3063. [Google Scholar]
- Luo, X. Evaluation of single-component chitosan fiber: From advanced materials to contemporary fashion manufacturing. Text. Res. J. 2020, 90, 125–134. [Google Scholar]
- Wang, J.T.; Li, L.L.; Feng, L. Directly obtaining pristine magnetic silk fibers from silkworm. Int. J. Biol. Macromol. 2014, 63, 205–209. [Google Scholar]
- Lin, J.Y.; Yang, Z.X.; Hu, X.X.; Hong, G.H.; Zhang, S.B.; Song, W. The Effect of alkali treatment on properties of dopamine modification of bamboo fiber/polylactic acid composites. Polymers 2018, 10, 403. [Google Scholar] [CrossRef]
- Zhang, J.Y.; Li, T.; Liu, T.Y.; Zhang, C.; Li, C.; Yu, C.; Xu, C.; Wang, G.; Cheng, C.; Xu, J. Preparation of an all-natural seaweed functionalized lyocell fiber: A scalable approach from nature to fabrics. Fibers Polym. 2024, 25, 4257–4269. [Google Scholar]
- Ju, J.P.; Yang, J.Z.; Zhang, W.C.; Wei, Y.T.; Yuan, H.; Tan, Y.Q. Seaweed polysaccharide fibers: Solution properties, processing and applications. J. Mater. Sci. Technol. 2023, 140, 1–18. [Google Scholar]
- Fang, Y.T.; Gan, F.; Dong, J.; Xin, Z.X.; Li, T.; Zhang, Q.H. Preparation of high-performance polyimide fibers with wholly rigid structures containing benzobisoxazole moieties. Chin. J. Polym. Sci. 2022, 40, 280–289. [Google Scholar]
- Luan, J.S.; Zhang, S.L.; Zhang, M.; Geng, Z.; Wang, Y.; Wang, G.B. Preparation and characterization of high-performance poly(ether ketone) fibers with improved spinnability based on thermotropic liquid crystalline poly(aryl ether ketone) copolymer. J. Appl. Polym. Sci. 2013, 130, 1406–1414. [Google Scholar]
- Liu, Y.P.; Zhang, M.J.; Liu, H.C.; Tian, L.; Liu, J.; Fu, C.F.; Fu, T.X. Properties of basalt fiber core rods and their application in composite cross arms of a power distribution network. Polymers 2022, 14, 2443. [Google Scholar] [CrossRef]
- Zhang, Z.; Wang, X.; Du, J.J. Functional modification of meta-aramid: A review. Mini-Rev. Orginic Chem. 2024, 21, 436–444. [Google Scholar]
- Yin, F.; Tang, C.; Wang, Q.; Xiong, L.; Tang, Y. Molecular dynamics simulations on the thermal decomposition of meta-aramid fibers. Polymers 2018, 10, 691. [Google Scholar] [CrossRef]
- Niu, Z.; Qi, S.; Shuaib, S.S.A.; Yuan, W. Flexible, stimuli-responsive and self-cleaning phase change fiber for thermal energy storage and smart textiles. Compos. Part B Eng. 2022, 228, 109431. [Google Scholar]
- Xing, S.J.; Xie, Y.T. Development and properties of thermochromic regenerated cellulose fibers and its fabric. Synth. Fibre 2019, 7, 23–27. [Google Scholar]
- Shi, M.; Lu, B.; Li, X.; Jin, X.; Ge, M. Thermochromic luminescent fiber based on yellow thermochromic microcapsules: Preparation, properties, and potential application areas. Cellulose 2021, 28, 5005–5018. [Google Scholar]
- Huang, S.R.; Chen, L.H.; Zhou, H.Q. Influence of Temperature on the temperature regulation performance of phase change thermostat fiber fabric. J. Beijing Inst. Cloth. Technol. (Nat. Sci. Ed.) 2018, 38, 16–23. [Google Scholar]
- Zhang, C.Y.; Wu, Z.N.; Wang, C.; Li, H.F.; Li, Z.H.; Lin, J.M. Hydrated negative air ions generated by air–water collision with TiO2 photocatalytic materials. RSC Adv. 2020, 10, 43420–43424. [Google Scholar] [PubMed]
- Li, Q.S.; Zhang, K.J.; Luo, J.Q.; Li, J.A.; Jiang, J.; Liang, Q.Q.; Jin, Y.X.; Liu, B. The research of far infrared flame retardant polyester staple fiber. IOP Conf. Ser. Mater. Sci. Eng. 2017, 167, 012002. [Google Scholar]
- Lai, C.C.; Jen, C.W.; Chang, Y.S.; Huang, K.S. Preparation and properties of multifunctional nylon 6 composite material. J. Compos. Mater. 2011, 45, 2707–2715. [Google Scholar]
- Zhang, M.X.; Zhang, J.S.; Lu, X.; Wu, J.B.; Wang, W.; Peng, J.J. Preparation and performance of a novel ZnO/TM/PET composite negative ion functional fiber. Polymers 2024, 16, 1439. [Google Scholar] [CrossRef]
- FZ/T 01086-2020; Textile Yarn Hairiness Determination Method Projection Counting Method. China Standards Press: Beijing, China, 2020.
- GB/T 4802.2-2008; Determination of Fabric Propensity to Surface Fuzzing to Pilling—Part 2: Modified Martindale Method. China Standards Press: Beijing, China, 2008.
- GB/T 3923.1-2013; Textiles—Determination of Tensile Properties of Fabrics—Part 1: Breaking Strength and Elongation at Break (Strip Method). China Standards Press: Beijing, China, 2013.
- GB/T 5453-1997; Determination of Air Permeability of Textile Fabrics. China Standards Press: Beijing, China, 1997.
- GB/T 12704.1-2009; Determination of Moisture Permeability of Textile Fabric. China Standards Press: Beijing, China, 2009.
- GB/T 30128-2013; Detection and Evaluation of the Occurrence of Negative Ions in Textiles. China Standards Press: Beijing, China, 2013.
- SN/T 2558.2-2011; Inspection Methods for Import and Export Functional Textiles Part II: Negative Ion Content. China Standards Press: Beijing, China, 2011.
- GB/T 30127-2013; Testing and Evaluation of Far-Infrared Properties of Textiles. China Standards Press: Beijing, China, 2013.
- FZ/T 73023-2006; Antimicrobial Knitwear Appendix D: Oscillating Method. China Standards Press: Beijing, China, 2006.
- Li, X.Q.; Liu, R.T.; Geng, C.J.; Hu, Z.D.; Feng, Y. Study on Fabric Feature and Air Permeability & Moisture Penetrability. Cotton Text. Technol. 2019, 4, 17–20. [Google Scholar]
- GB/T41788-2022; Multi-Functional Knitted Products. China Standards Press: Beijing, China, 2022.
- Li, J.H.; Jin, S.L. Mechanism of Far Infrared Emission from Mineral Tourmaline Fine Powders. Adv. Mater. Res. 2008, 58, 77–82. [Google Scholar]
- Li, J.H.; Jun, P.M.; Jin, S.L.; Kun, G.; Yan, D.; You, D.Y. Electric Dipole Characteristics of Mineral Tourmaline Superfine Powders and its Properties of Far Infrared Emission. Adv. Mater. Res. 2010, 178, 129–132. [Google Scholar]
- GB/T 20944.3-2008; Evaluation of Antimicrobial Properties of Textiles—Part 3: Oscillation Method. China Standards Press: Beijing, China, 2008.










| Process Condition | 1st Area Screw Temp. | 2nd Area Screw Temp. | 3rd Area Screw Temp. | 4th Area Screw Temp. | Screw Flange Temp. | Metering Pump Temp. | 1st Area Hot Roll Temp. | 2nd Area Hot Roll Temp. | 3rd Area Hot Roll Temp. |
|---|---|---|---|---|---|---|---|---|---|
| SV(Actual temp) (°C) | 202 | 260 | 270 | 270 | 269.9 | 265.2 | 65.1 | 66.3 | 68.2 |
| PV(Set temp) (°C) | 200 | 260 | 270 | 270 | 270.0 | 65.0 | 65.0 | 65.0 | 65.0 |
| Process Condition | Extruder Screw Frequency (Hz) | Extrusion Screw Current (A) | Metering Pump Speed (r/min) | Oiling Speed (r/min) | 1st Area Hot Roll Speed (r/min) | 2nd Area Hot Roll Speed (r/min) | 3rd Area Hot Roll Speed (r/min) | Winding Speed (r/min) | Winding Angle (°) | Theoretical Drawing Ratio |
|---|---|---|---|---|---|---|---|---|---|---|
| Process parameter | 2.00 | 8.90 | 5.0 | 3.0 | 440.0 | 700.0 | 760.0 | 800.0 | 5.0 | 1.8 |
| Fabric Sample | Yarn Combination | Yarn Ratio (%) | Square Meter Weight (g/m2) | Number of Stitches on the Front of the Fabric (Stitches/5 cm) | Number of Stitches on the Back of the Fabric (Stitches/5 cm) | ||
|---|---|---|---|---|---|---|---|
| Transverse Density | Longitudinal Density | Transverse Density | Longitudinal Density | ||||
| A1 | wool/Y1 | 50:50 | 250 | 30 | 40 | 30 | 40 |
| A2 | wool/Y4 | 50:50 | 250 | 30 | 40 | 30 | 40 |
| Fabric Sample | Yarn Ratio (%) | Equipment Operating Parameter | ||||
|---|---|---|---|---|---|---|
| ZnO/TM/PET Yarn | Spandex Yarn | Feeder (F) | Intube Diameter (Inch) | Machine Gauge (Needles) | Machine Speed (r/min) | |
| B1 | 78 | 22 | 84 | 34 | 28 | 25 |
| B2 | 87 | 13 | 84 | 34 | 28 | 25 |
| Fabric Sample | Breaking Strength (N) | Breaking Extension (mm) | ||
|---|---|---|---|---|
| Weft | Warp | Weft | Warp | |
| A1 | 310.26 | 251.17 | 58.41 | 137.69 |
| A2 | 168.17 | 126.43 | 40.01 | 67.84 |
| B1 | 311.02 | 419.94 | 390.24 | 276.26 |
| B2 | 353.62 | 393.86 | 319.01 | 210.92 |
| Number of Frictions | 500 | 1000 | 2000 | 5000 | 7000 | ||||||
|---|---|---|---|---|---|---|---|---|---|---|---|
| Test Item | Fuzzing | Pilling | Fuzzing | Pilling | Fuzzing | Pilling | Fuzzing | Pilling | Fuzzing | Pilling | |
| A1 | Right Side | 5 | 5 | 4.5 | 4.9 | 4.3 | 4.6 | 4 | 4.2 | 3.8 | 4 |
| Reverse Side | 5 | 5 | 4.5 | 4.9 | 4.3 | 4.6 | 4 | 4.2 | 3.8 | 4 | |
| A2 | Right Side | 5 | 5 | 4.5 | 4.9 | 4.3 | 4.6 | 4 | 4.2 | 3.8 | 4 |
| Reverse Side | 5 | 5 | 4.5 | 4.9 | 4.3 | 4.6 | 4 | 4.2 | 3.8 | 4 | |
| B1 | Right Side | 5 | 5 | 4.8 | 5 | 4.5 | 4.9 | 4.2 | 4.6 | 4 | 4.2 |
| Reverse Side | 5 | 5 | 4.8 | 5 | 4.5 | 4.9 | 4.2 | 4.6 | 4 | 4.2 | |
| B2 | Right Side | 5 | 5 | 4.8 | 5 | 4.5 | 4.9 | 4.2 | 4.6 | 4 | 4.2 |
| Reverse Side | 5 | 5 | 4.8 | 5 | 4.5 | 4.9 | 4.2 | 4.6 | 4 | 4.2 | |
| Microbial species | Staphylococcus aureus | Escherichia coli | Candida albicans | ||||
| Number of washes/times | 50 | 100 | 50 | 100 | 50 | 100 | |
| Antimicrobial Rate (%) | Standard requirement | ≥80 | ≥90 | ≥70 | ≥80 | ≥60 | ≥70 |
| A1 | 98 | 95 | 95 | 91 | 85 | 81 | |
| A2 | 97 | 94 | 95 | 91 | 85 | 81 | |
| B1 | 98 | 95 | 95 | 91 | 85 | 81 | |
| B2 | 97 | 94 | 95 | 91 | 85 | 81 | |
| Evaluation result | antimicrobial | ||||||
| Microbial Name | Control Sample | Sample A1 | Control Sample | Sample B1 | ||
|---|---|---|---|---|---|---|
| Before Washed | After Washed 50 Times | Before Washed | After Washed 50 times | |||
| Staphylococcus aureus | ![]() | ![]() | ![]() | ![]() | ![]() | ![]() |
| Escherichia coli | ![]() | ![]() | ![]() | ![]() | ![]() | ![]() |
| Candida albicans | ![]() | ![]() | ![]() | ![]() | ![]() | ![]() |
Disclaimer/Publisher’s Note: The statements, opinions and data contained in all publications are solely those of the individual author(s) and contributor(s) and not of MDPI and/or the editor(s). MDPI and/or the editor(s) disclaim responsibility for any injury to people or property resulting from any ideas, methods, instructions or products referred to in the content. |
© 2025 by the authors. Licensee MDPI, Basel, Switzerland. This article is an open access article distributed under the terms and conditions of the Creative Commons Attribution (CC BY) license (https://creativecommons.org/licenses/by/4.0/).
Share and Cite
Zhang, Y.; Zhang, M.; Zhang, J.; Wu, J.; Peng, J. Development and Performance of Negative Ion Functional Blended Yarns and Double-Sided Knitted Fabrics Based on ZnO/TM/PET Fiber. Polymers 2025, 17, 905. https://doi.org/10.3390/polym17070905
Zhang Y, Zhang M, Zhang J, Wu J, Peng J. Development and Performance of Negative Ion Functional Blended Yarns and Double-Sided Knitted Fabrics Based on ZnO/TM/PET Fiber. Polymers. 2025; 17(7):905. https://doi.org/10.3390/polym17070905
Chicago/Turabian StyleZhang, Yingzi, Mengxin Zhang, Jishu Zhang, Jianbing Wu, and Jiajia Peng. 2025. "Development and Performance of Negative Ion Functional Blended Yarns and Double-Sided Knitted Fabrics Based on ZnO/TM/PET Fiber" Polymers 17, no. 7: 905. https://doi.org/10.3390/polym17070905
APA StyleZhang, Y., Zhang, M., Zhang, J., Wu, J., & Peng, J. (2025). Development and Performance of Negative Ion Functional Blended Yarns and Double-Sided Knitted Fabrics Based on ZnO/TM/PET Fiber. Polymers, 17(7), 905. https://doi.org/10.3390/polym17070905